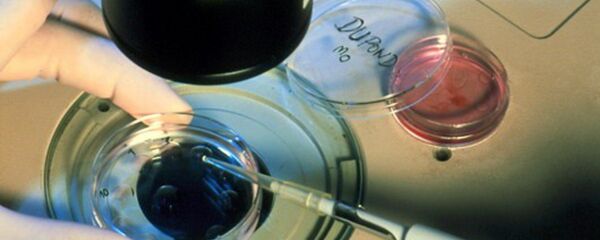
A 30-year-old woman has successfully given birth to a child using an egg she had frozen 12 years ago A 30-year-old woman has successfully given birth to a child using an egg she had frozen 12 years ago - Sputnik International

"There aren't enough birds in California to meet the state's egg demands. [The new regulations] could reduce the already short supply, and create an egg shortage locally," an analyst at Urner Barry business publisher Brian Moscogiuri said Tuesday, as quoted by the newspaper.
The new legislation will come into effect in 2015.
According to the previous regulations each hen required 67 square inches, while the new ones would oblige farmers to allocate 116 square inches to each bird, which is a 70 percent increase.
Moreover, the national market might be affected, as a large share of eggs consumed in California are supplied by farmers from other states. If they decide to follow the new Californian rules and keep selling their produce to buyers in the state, their expenses will be so high they will be forced to increase the prices nationwide, The Washington Post argued.
Otherwise, farmers might decide to ignore the new regulations and opt not to sell their produce in California at all. In this case, the resulting surplus will lead to a drop in prices at the national level.
The US egg market has been unstable even before the adoption of the new regulations. The wholesale prices across the country have increased by 35 percent since the beginning of 2014.